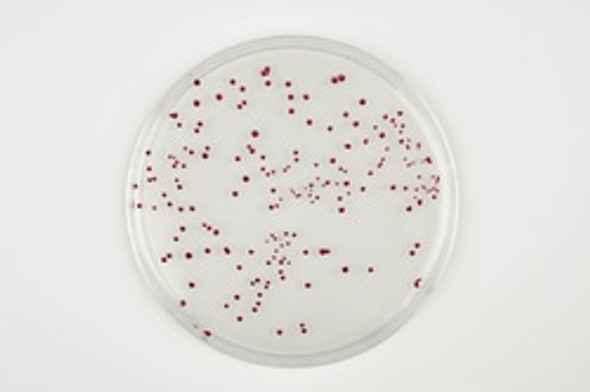
Oxoid™ Brilliance™ CampyCount Agar 90mm Monoplate Pk 10

Frequently bought together:
Description
Accurately enumerate Bacillus cereus in food samples using Thermo Scientific™ MYP Selective Agar (Mannitol Egg Yolk Polymyxin). This selective and differential medium is proven highly effective, conforming to ISO 7932 and delivering reliable results even with challenging organism cell ratios.
MYP Agar provides clear diagnostic features crucial for identifying B. cereus:
- Differentiation: Relies on the characteristic failure of B. cereus to utilize mannitol and the ability of most strains to produce Phospholipase C.
- Identification: Phospholipase C activity results in an opaque halo surrounding the colonies, making presumptive identification straightforward.
- Selectivity: The inclusion of Polymyxin B effectively inhibits most Gram-negative bacteria, ensuring the selective isolation of the target organism.
MYP Agar offers a reliable method for detecting B. cereus, a recognized causative agent of food poisoning, and represents an improvement over older, less specific techniques like blood agar.